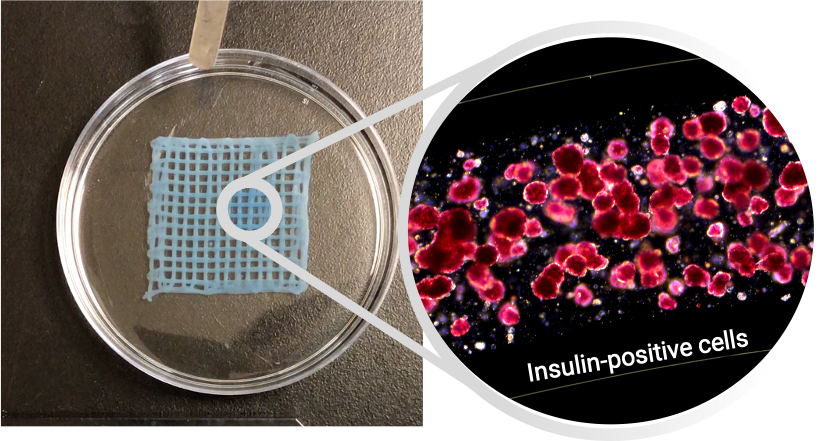

Bioprinted immune-protective islet-containing tissues successfully regulate blood glucose in rodent models of type 1 diabetes
Valerio Russo1, Reza Jalili1, Sheng Pan1, Navid Hakimi1, Rishima Agarwal1, Yang Yu1, Kamal Khan1, Kaushar Jahan1, Shogo Ida2, Emily Wilts2, Cara Ellis2, Priye Iworima2, Elisa Tran2, Mei Tang2, Timothy Kieffer2, Simon Beyer1, Eric Roos1, Tamer Mohamed1, Spiro Getsios1, Sam Wadsworth1.
1Aspect Biosystems, Vancouver, BC, Canada; 2Department of Cellular & Physiological Sciences, Life Sciences Institute, University of British Columbia, Vancouver, BC, Canada
Introduction: Type 1 diabetes (T1D) is a disease characterized by elevated blood glucose due to insufficient insulin release from pancreatic β-cells. Transplantation of cadaveric islets demonstrates that cell therapy can fully reverse hyperglycemia. However, limited cell supply, immune rejection of implanted allogeneic cells, and cell survival represent major challenges. Cell encapsulation has great potential to overcome these challenges by blocking immune cell access to the grafts while allowing nutrient exchange and secreted products from the implanted cells to be delivered to the body. In this study, we use a unique microfluidic bioprinting technology to precisely control the placement of cells and biomaterials within 3D tissues with micro-architectures optimized for cellular fitness and immune protection.
Methods: Living tissues consisting of fibres with a cell-containing core and immune-protective alginate-based shell were generated using Aspect Biosystems’ RX1 bioprinter technology. Core-shell fibres with reaggregated primary human pancreatic islets or embryonic stem cell-derived β-cells were tested in vitro using viability and functional (glucose-stimulated insulin secretion, GSIS) assays. Bioprinted tissues were then implanted into the IP space or omentum of streptozotocin (STZ)-induced diabetic mice and rats, respectively. Glucose homeostasis, body weight, and human C-peptide secretion were monitored for up to 3 months following implantion. Retrieved grafts were fixed and analyzed by histology (H&E, Masson’s trichrome stain) and immunohistochemistry (α-SMA, CD45) to quantify fibrotic encapsulation and immune cell infiltration.
Results: Bioprinted tissues supported viability and dynamic insulin secretion of cells in vitro up to 28 days. When transplanted into immunodeficient and immunocompetent diabetic rodents, bioprinted tissues containing reaggregated human islets successfully regulated blood glucose for up to 3 months (Figure 1), although normoglycemia was only sustained in a subset of immunocompetent animals and associated with variable fibrosis. Post-retrieval viability stain, assessment of GSIS, and histology revealed high viability and functionality of implanted cells, and the absence of leukocyte infiltration through the shell.
Discussion: This is the first study showing a fully 3D bioprinted tissue composed of a core/shell fibre can successfully deliver a therapeutic dose of xenogeneic cells into a diabetic animal (Figure 2). The unique features of the microfluidic technology were leveraged to bioprint an implantable and retrievable tissue patch that merges the benefits of a single fibre (cell fitness, access to nutrients, immune-protection, perm-selectivity) with those provided by a 3D structure (retrievability, ease of implant, structural integrity). The promising results obtained in rodent studies warrant further investigation to minimize fibrosis and explore the scaling-up of bioprinted tissues in large animal models of T1D.

NRC-IRAP. NSERC. Stem Cell Network. Genome BC.